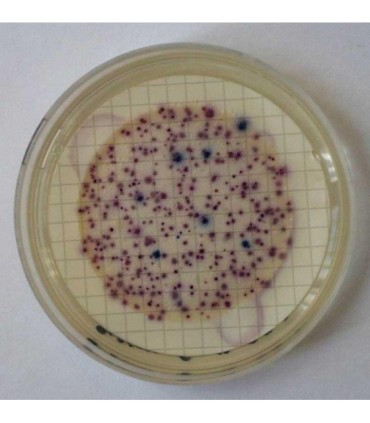
Clostridium Perfringens En Agua

Clostridium perfringens, es una bacteria anaeróbica Gram-positiva, capsulada, esporulada e inmóvil que se encuentra ampliamente distribuida en el ambiente, de gran plasticidad ecológica.
Se encuentra en los intestinos de los seres humanos y de varios animales homeotermos, en el suelo, en el agua, en los alimentos (sobre todo en las carnes que no están bien cocinadas), entre otros.
Las enfermedades causadas pueden ser fatales, este parámetro es requerido solo si el agua procede total o parcialmente de agua superficial (agua en contacto con la atmósfera, como las de arroyo, ríos, estanques y embalses.
La enumeración de Clostridium perfringens se basa en la filtración de un volumen especifico de muestra de agua a traves de un filtro de membrana con un tamaño de poro 0,45µm, suficiente para detener las bacterias. La membrana se incuba a 44°C ±1°C por 21 ±3 horas en un agar diferencial selectivo luego se cuentan las colonias caracteristicas.
Posteriormente se realiza una prueba de confirmación para calcular el recuento de colonias por 100 ml de muestra.